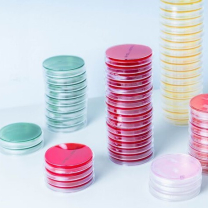
Лаборатория микробиологии

Наши лаборатории
Исследования в лабораториях компании ДІЛА осуществляются на высокотехнологичном оборудовании признанных лидеров в своей области. Используются реагенты мировых производителей, подтвердивших диагностическую состоятельность: Siemens, Abbott, bioMerieux, Beckman Coulter.
Среди украинских лабораторий, МЛ ДІЛА первой построила систему менеджмента качеством, соответствующую международным стандартам (ISO 9001:2008 и ISO 15189:2012). Лабораторные процессы организованы с учетом мировых требований к управлению качеством – TQM (Total Quality Management).
Общее управление работой автоматических анализаторов и всех этапов исследований осуществляется с помощью лабораторной информационной системы (ЛИС) Analytix, CGM Lab, Швеция. Для оборудования бренда Siemens используется дополнительное программное обеспечение ЛИС Centralink, США. Единая информационная система позволяет отслеживать путь конкретного образца с момента взятия биоматериала и до получения результатов, контролировать каждый процесс, осуществлять техническую валидацию и клиническую верификацию.
Компания регулярно участвует во внешних системах оценки качества – EQAS (США), RIQAS (Великобритания) и национальных программах межлабораторных сравнений результатов исследований. Ежедневно осуществляется мониторинг производственных аналитических процессов по системам BIO-RAD (США) и Randox (Великобритания), который обеспечивает стабильное качество результатов исследований.
В лабораториях работают высококвалифицированные специалисты, обладающие экспертными знаниями, опытом проведения исследований и интерпретации результатов. Сотрудники лабораторий имеют сертификаты в соответствии с национальными требованиями. Регулярно посещают тренинги и курсы повышения квалификации украинских и зарубежных обучающих центров, крупных европейских лабораторий: Швеции, Испании, Франции.